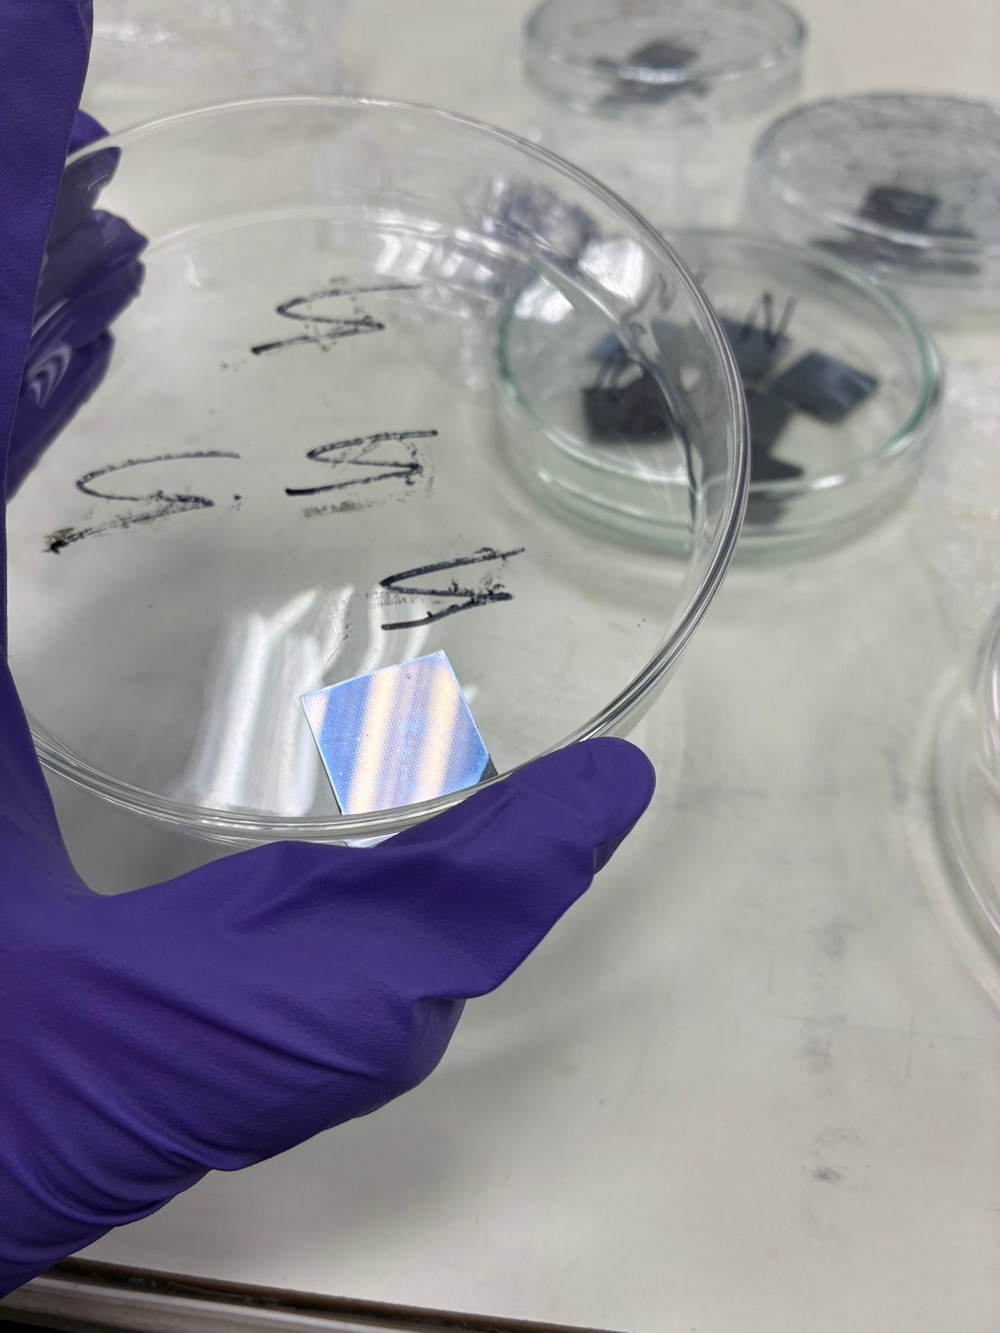

| |
 |
|
俄羅斯阿基米德國際發明展本校勇奪5金1特別獎 |
| | | |
2026年第29屆「俄羅斯阿基米德國際發明展」於115年3月17日至3月19日,在莫斯科Amber Plaza展覽中心盛大舉行,此屆展覽共有來自伊朗、沙烏地阿拉伯、越南、柬埔寨、塞爾維亞等24個國家、超過500件創新發明作品同場競技,國立雲林科技大學有5件作品參展,榮獲5面金獎及1面特別獎,獲獎率達百分之百。 |
| | | | |
| | | |
化學工程與材料工程系教授粘譽薰團隊,研發創新技術-開發含可見光響應型CuWO₄ /TiO₂ /Coconut Shell Biochar光觸媒之靜電紡絲纖維膜,本研究研發出可見光響應的高效複合光觸媒纖維膜。技術核心利用溶膠-凝膠法構建CuWO₄/TiO₂異質結構,突破傳統二氧化鈦僅能吸收紫外光的限制,使其在自然光下具備強大氧化還原力。透過靜電紡絲技術將觸媒與高分子結合製成「三明治結構」納米纖維膜。此設計結合椰殼生物碳的高比表面積,實現「先吸附富集、後光催化降解」機制,不僅顯著提升淨水效率,更解決粉末觸媒難以回收與二次污染的痛點,為低耗能水處理提供具實務價值的全新方案,此項研發創新技術,獲得金獎。粘老師團隊另一創新技術-透過靜電紡絲原位自組裝g-C3N4-TiO2 異質結構奈米纖維以實現高效率染料敏化太陽能電池,獲得金獎及特別獎。藉由靜電紡絲技術製備出原位自組裝 g-C3N4-TiO2 異質結構奈米纖維,此方法能夠改善加入 g-C3N4片狀結構導致纖維結構不均勻及顆粒過大造成的電子傳輸不利等負面影響,並透過奈米纖維結構作為散射層改善TiO2光陽極的光伏性能,並將此新型光陽極運用染料敏化太陽能電池中,於低光照強度下進行光伏發電。 |
| | | | |
| | | |
電子工程系教授許智傑團隊,研發創新技術-具大記憶視窗與高資料保存能力之氧化鉿鋯電阻式記憶體元件,本研究成功製備了高性能的Cu/HZO/n⁺-Si記憶體元件。作為三元材料的HZO具有高介電常數,能有效降低漏電流並擁有較大的元件記憶視窗。藉由HZO優異的可調性,透過改變電阻轉換層厚度與氧空缺濃度,本研究實現了高達105的記憶視窗,且具備優異的資料保存能力。此研究展現HZO薄膜應用在RRAM主動層帶來的高性能,為RRAM的發展提供參考數據與新穎性,獲得金獎。 |
| | | | |
| | | |
電機工程系助理教授陳靜茹團隊研發創新技術- SMART-SWEEP:具動態道路權重分級之智慧道路清掃最佳化系統,針對城市清潔痛點,開發基於「髒污權重」的動態排程演算法。突破傳統齊頭式清掃,依區域落塵量(如工業區與住宅區)設定高低頻作業權重,並整合取水點規劃,大幅降低無效里程。系統具備 Web-GIS 視覺化模擬平台,管理者可預覽動態軌跡、檢核衝突,並一鍵生成 KML 導航檔供司機使用。實證顯示能將空跑率大幅地降低,實現數據驅動的精準治理,顯著提升調度彈性與燃油效益,獲得金獎。 |
| | | | |
| | | |
電子工程系陳錫釗教授團隊,研發創新技術-用於多巴胺檢測的感測電極,本發明提供一種用於快速檢測多巴胺濃度的感測電極,結構包含一導電基板及塗佈於其感測區上的多巴胺檢測塗層。導電基板具有導電薄膜,薄膜上區分為連接區與感測區。多巴胺檢測塗層由鐵基金屬有機框架 MIL‑101(Fe) 粉末與貴金屬奈米粒子粉末混合組成,所述奈米粒子可為金奈米粒子、銀奈米粒子或金核銀殼奈米粒子。藉由奈米粒子的侷域表面電漿修飾磁性鐵基金屬有機框架 MIL‑101(Fe)提升感測能力。本發明可作為對多巴胺進行高靈敏度且快速的電化學檢測,獲得金獎。 |
| | | | |
| | | |
本校表示,將持續不斷投入資源,積極培育具創新能力與實務應用價值的優秀發明團隊,並鼓勵師生勇於挑戰國際舞台,期望透過參與各類國際發明展與競賽,拓展視野、提升能見度。同時,也希望藉由這些優異表現,為學校累積更多榮譽,進一步提升台灣在全球創新領域的地位與影響力,讓世界看見本校與台灣的研發實力與創意能量。 |
| | | | |
| | | |

I-V characteristics of the RRAM-具大記憶視窗與高資料保存能力之氧化鉿鋯電阻式記憶體元件-電子系-許智傑老師
|
| | | | |
| | | |

SMART-SWEEP:具動態道路權重分級之智慧道路清掃最佳化系統-電機工程系-陳靜茹老師
|
| | | | |
| | | |
The RRAM-具大記憶視窗與高資料保存能力之氧化鉿鋯電阻式記憶體元件-電子系-許智傑老師
|
| | | | |
| | | |

Yuntech 作品攤位
|
| | | | |
| | | |
(楊宜蓉 EXT:2513) |